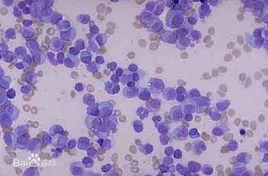
骨髓瘤細胞 骨髓瘤細胞

哺乳動物感染抗原後,其體內會形成相應的B淋巴細胞,B淋巴細胞能分泌相應的抗體凝聚或殺死這些抗原。動物在免疫反應的過程中,每一種B淋巴細胞能分泌一種特異性抗體,要想獲得大量的特異性抗體,必須使能分泌該單一抗體的B淋巴細胞大量增殖。B淋巴細胞具有產生單一抗體的能力,但不能在體外增殖;骨髓瘤細胞是一種癌細胞,它能在體外培養條件下無限增殖,但不能產生抗體。因此,把一種B淋巴細胞與骨髓瘤細胞進行細胞融合,產生雜交瘤細胞,它會兼有兩個親本細胞的特性──在體外培養條件下能不斷增殖,同時能產生出某種特異性的抗體。
相關詞條
-
骨髓瘤
骨髓瘤(MM)是一種惡性漿細胞病,分為單發和多發性,其腫瘤細胞起源於骨髓中的漿細胞,而漿細胞是B淋巴細胞發育到最終功能階段的細胞。因此多發性骨髓瘤可以歸...
疾病概述 病因介紹 診斷情況 主要症狀 臨床表現 -
骨髓瘤蛋白
骨髓瘤蛋白,可通過骨髓瘤蛋白的分析獲得有關免疫球蛋白初級結構的大部分知識。
-
冒煙型骨髓瘤
當冒煙型骨髓瘤發展為進展性骨髓瘤時,再予化療。 冒煙型骨髓瘤發展為進展性骨髓瘤的中位時間約為26O.8%,若其PCLI
簡介 診斷標準 治療 -
骨硬化骨髓瘤
POEMS綜合徵亦稱(骨硬化性骨髓瘤)這病的臨床表現中的:慢性多發性神經病。見於所有患者,也是最常見的首發症狀,往往呈進行性、對稱性感覺、運動損害,從四...
治療方法 -
不分泌型骨髓瘤
多發性骨髓瘤的1%-3%,不分泌型骨髓瘤可分為2種亞型:一種是瘤細胞合成...骨髓瘤在臨床上有骨髓中瘤細胞浸潤,貧血,骨痛,病理性骨折,高鈣血症...%且有典型骨髓瘤細胞出現.2.多發性溶骨性病變,這兩項是診斷不分泌型...
簡介 診斷標準: 治療 -
B細胞淋巴瘤
B細胞淋巴瘤是B細胞發生的實體腫瘤。包括霍奇金淋巴瘤和非霍奇金淋巴瘤。其分型眾多,經典霍奇金淋巴瘤和結節性淋巴細胞為主型霍奇金淋巴瘤,現在被認為是起源於...
疾病分類 疾病預後 B細胞淋巴瘤各論 -
雜交瘤細胞
雜交瘤細胞(hybridoma)是一種在製備單克隆抗體過程中,用骨髓瘤細胞和B淋巴細胞融合而成的細胞。雜交瘤細胞一般通過瘤細胞培養來製備。 雜交瘤技術是...
介紹 製作方法 -
腫瘤細胞
腫瘤細胞實質就是腫瘤。腫瘤組織由實質和間質兩部分構成,腫瘤實質是腫瘤細胞,是腫瘤的主要成分,具有組織來源特異性。它決定腫瘤的生物學特點以及每種腫瘤的特殊...
介紹 類型 構成 主要特徵 飲食調理